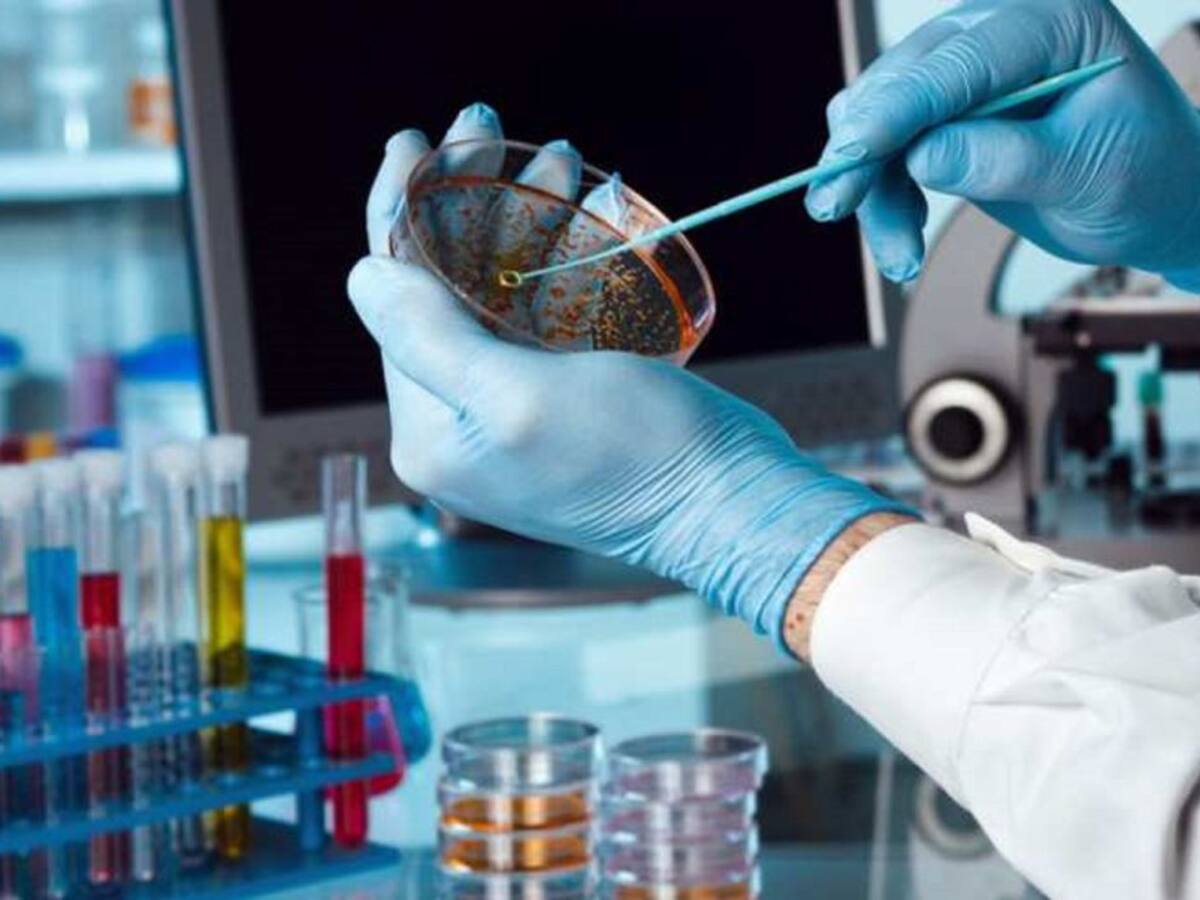

Cort abre el plazo de inscripción de los mercados temporales
Los interesados pueden inscribirse en las oficinas de Atención al Ciudadano aportando la documentación necesaria
30/09/2019 - 14:35
Marta Martínez
Palma
Selecciona tu emisora

Los interesados pueden inscribirse en las oficinas de Atención al Ciudadano aportando la documentación necesaria
30/09/2019 - 14:35
Marta Martínez
Palma
Y suponen el 30% de los medicamentos que se utilizan actualmente
29/09/2019 - 14:50
Marta Martínez
Palma

El portavoz Alberto Jarabo ha explicado que ya les han devuelto unas 40 llaves de los negocios de las galerías de la Plaza Mayor de Palma
25/09/2019 - 14:40
Marta Martínez
Palma

Además, la gerencia de Urbanismo ha abierto cinco expedientes sancionadores a los propietarios, el promotor, el ingeniero y la empresa constructora del Megapark por un valor total de 2.160.000 euros
24/09/2019 - 13:48
Marta Martínez
Palma

El 84% de toda esta comida que se desperdicia, se tira directamente a la basura
22/09/2019 - 14:49
Marta Martínez
Palma

Los negocios se han compretido a ir remplazando, de forma progresiva, los plásticos de un solo uso para avanzar hacia un barrio más sostenible
19/09/2019 - 14:36
Marta Martínez
Palma

Se trata, dicen desde Afedeco, de un convenio que ofrece estabilidad y garantiza "paz social" entre las 15.000 empresas de las islas relacionadas con la actividad comercial y los trabajadores
18/09/2019 - 14:20
Marta Martínez
Palma

"Todo esto no servirá de nada si no llega la nueva depuradora financiada por el gobierno", advierte el responsable de la empresa municipal, Ramón Perpinyà, ya que la actual funciona desde hace casi 50 años
13/09/2019 - 13:53
Marta Martínez
Palma
Ahora en directo
Cadena SER
00:00 - 23:59
00:00 - 23:59
Otros directosCadena SER
00:00 - 23:59
Podcast
Síguenos en
Otros episodios
Cualquier tiempo pasado fue anterior
Tu audio se ha acabado.
Te redirigiremos al directo.
5 "